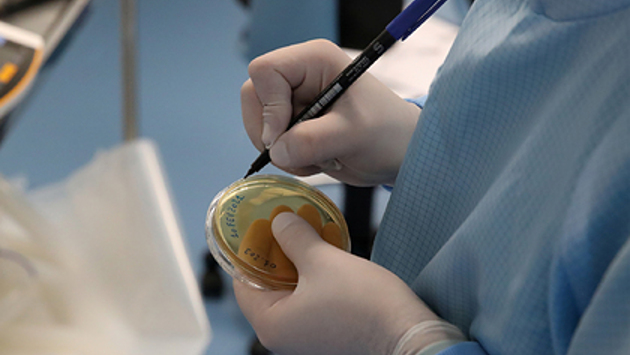

Новый штамм коронавируса, похожий на южноафриканский, обнаружили в соседней с Россией Финляндии. Об этом сообщает местная газента Turun Sanomat.
Случаи заражения новой разновидностью коронавируса были зафиксированы среди студентов города Турку, расположенного на юго-западе страны. Отмечается, что новый штамм может быть более заразным, что объяснило бы прирост случаев в городе. Однако никому из тех, кто им заразился, не понадобилась госпитализация. Новая разновидность вируса напоминает по характеристикам южноафриканскую, однако из-за наличия в ней новых мутаций ученые предполагают, что речь может идти о новом штамме.
Ранее сообщалось, что новый штамм коронавируса с двойной мутацией обнаружили в Индии. Пока у индийских властей недостаточно информации для того, чтобы установить прямую связь между появлением мутаций и быстрым ростом случаев заболевания в некоторых штатах страны.
В феврале американские ученые установили, что мутации в британском, южноафриканском и бразильском штаммах коронавируса увеличивают его заразность до восьми раз. По последним данным, британский штамм обнаружен уже в 101 стране, южноафриканский — в 51 стране, а бразильский штамм — в 30.